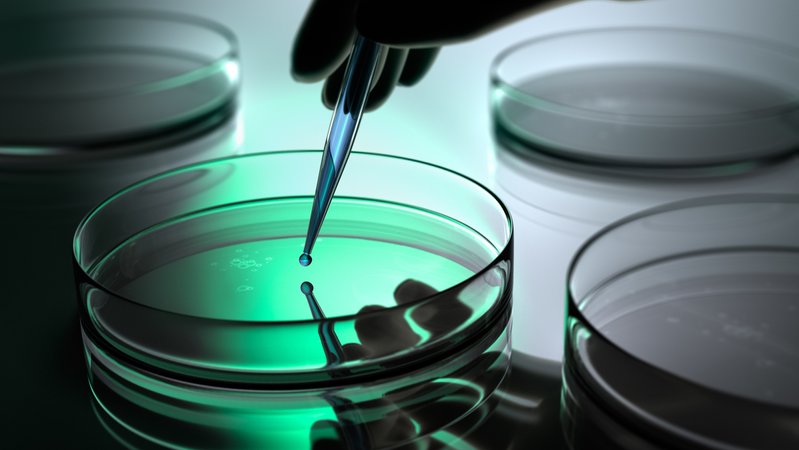
Symbolbild: Petrischale in einem Labor | Bild: stock.adobe.com/peterschreiber.media Symbolbild: Petrischale in einem Labor

Zwei Männer aus dem oberbayerischen Landkreis Pfaffenhofen an der Ilm haben sich mit dem seltenen Borna-Virus infiziert – einer von ihnen ist inzwischen verstorben, der andere liegt auf der Intensivstation. Die Fälle sorgen für Verunsicherung in der Region: Wie gefährlich ist das Virus? Wie wird es übertragen – und wie kann man sich schützen? Die Behörden ermitteln, eine Expertin ordnet ein.
Was genau ist in Pfaffenhofen passiert?
Zwei Männer aus Pfaffenhofen haben sich mit dem seltenen, aber potenziell tödlichen Bornavirus infiziert. Einer ist bereits verstorben, der andere wird derzeit auf einer Intensivstation in Bayern behandelt.
Wer sind die Infizierten?
Bei dem Verstorbenen und dem noch erkrankten Patienten handelt es sich um zwei Männer Mitte 50 – beide aus Pfaffenhofen an der Ilm. Das bestätigt Landrat Albert Gürtner. Zwar leben beide in derselben Stadt, jedoch in räumlicher Entfernung zueinander. Bisher seien keine Gemeinsamkeiten erkennbar, so Gürtner. Die Männer seien weder verwandt noch – nach aktuellem Kenntnisstand – enger befreundet.
Wie geht es dem zweiten Infizierten im Krankenhaus?
Wie es dem Infizierten geht, ist derzeit unklar. Er wird intensivmedizinisch behandelt.
Wie kam es zur Ansteckung – und könnten Mäuse dabei eine Rolle gespielt haben?
Die größte Ansteckungsgefahr für den Menschen mit dem Borna-Virus besteht beim Kontakt mit Feldspitzmäusen oder deren Ausscheidungen wie Urin, Kot und Speichel. Bisher gilt nur die Feldspitzmaus als Überträger des Virus.
Wie sich die beiden Männer mit dem Borna-Virus angesteckt haben, ist bislang unklar. Die Übertragungswege von Mensch zu Mensch gelten nach Angaben des Bayerischen Landesamts für Gesundheit und Lebensmittelsicherheit (LGL) als ausgeschlossen. Ob und in welchem Maß die beiden Erkrankten beruflich oder privat Kontakt zur Natur hatten, ist derzeit ebenfalls noch offen.
Das Gesundheitsamt Pfaffenhofen ermittelt gemeinsam mit dem LGL. Doch die Suche nach dem Infektionsweg gestaltet sich schwierig – die Ansteckung kann Wochen oder sogar Monate zurückliegen.
Dass innerhalb kurzer Zeit gleich zwei Fälle im Landkreis Pfaffenhofen auftreten, halten Fachleute für ungewöhnlich – aber möglicherweise für einen Zufall.
Wie gefährlich ist das Borna-Virus und wie viele Fälle gibt es pro Jahr?
Im Interview mit BR24 betont die Epidemiologin des Landratsamts für Gesundheit und Lebensmittelsicherheit, Dr. Merle Böhmer, dass das Borna-Virus (BoDV-1-Infektionen) eine sehr seltene Krankheit sei: "Wir sprechen hier von zwei bis fünf oder sechs Erkrankungsfällen pro Jahr, die das Robert Koch-Institut bisher berichtet hat." Dennoch sei es verständlich, dass sich die Bevölkerung Sorgen mache, da es sich um eine sehr tödliche Krankheit handle.
Im Video: Wie gefährlich ist das Bornavirus wirklich?
Wie gefährlich ist das Bornavirus?
Wie macht sich eine Infektion bemerkbar?
Expertin Böhmer erklärt, Infizierte würden zunächst unspezifische Symptome wie Fieber oder Kopfschmerzen entwickeln. "Wenn dann zusätzlich neurologische Symptome auftreten, zum Beispiel Gangstörungen, epileptische Anfälle oder auch Sprachstörungen, dann sollte man einen Arzt aufsuchen." Betroffene Personen werden zudem auch als in ihrem Wesen verändert beschrieben, erklärt Böhmer.
Wie wird das Borna-Virus übertragen?
Wie es zur Übertragung vom Wirt – der Feldspitzmaus – zum Menschen kommt, ist noch nicht klar, werde aber gerade erforscht, erklärt Böhmer: "Was man aber zu den Schutzmaßnahmen sagen kann, ist, dass es auf jeden Fall das Risiko verringert, indem man den Kontakt zu Spitzmäusen und deren Ausscheidungen nach Möglichkeit vermeidet." Tote Spitzmäuse, Mäuse oder Kleinsäuger soll man laut Böhmer niemals anfassen.
Das Verbreitungsgebiet der Feldmaus ist laut Expertin Böhmer fast ganz Europa, das Verbreitungsgebiet des Virus innerhalb der Feldspitzmauspopulation hingegen ist regional begrenzt: "In Bayern gibt es ein Haupt-Endemie-Gebiet, und dann zieht sich das in Deutschland korridorartig nach Norden hoch und dehnt sich ein bisschen nach Osten aus."
Wie sollen Spitzmäuse entsorgt werden?
Als Maßnahmen zur Entsorgung von Spitzmäusen oder deren Kot nennt Böhmer FFP2- oder FFP3-Masken, Handschuhe, Desinfektionsmittel und einen Ganzkörperoverall, den man danach entsorgen kann: "Zum Beispiel, wenn eine Katze so eine tote Spitzmaus in die Wohnung geschleppt hat, dann sollte man auf jeden Fall eine Maske aufziehen, sich Handschuhe anziehen, die Spitzmaus dann mit einem Desinfektionsmittel oder einem Reinigungsmittel benetzen, in eine Tüte packen, verknoten und dann entsorgen."
Wo können sich Bürger in Pfaffenhofen informieren?
In Pfaffenhofen herrscht zum Teil Verunsicherung, wie eine BR-Umfrage zeigt (Audio unten). Das Landratsamt Pfaffenhofen informiert auf seiner Website über Schutzmöglichkeiten gegen das seltene Borna-Virus. Zusätzlich bietet die Behörde am Donnerstagabend um 19 Uhr eine Live-Schalte an. Bürgerinnen und Bürger können dabei ihre Fragen direkt an Fachleute richten. Die Teilnahme ist online möglich – der Zugang erfolgt über die Website des Landratsamts.
Im Audio: Sorgen in Pfaffenhofen wegen Borna-Infektionen
Pfaffenhofen an der Ilm (Symbolbild)
Das ist die Europäische Perspektive bei BR24.
"Hier ist Bayern": Der BR24 Newsletter informiert Sie immer montags bis freitags zum Feierabend über das Wichtigste vom Tag auf einen Blick – kompakt und direkt in Ihrem privaten Postfach. Hier geht’s zur Anmeldung!